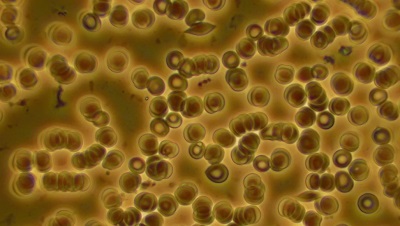
Снимка 12
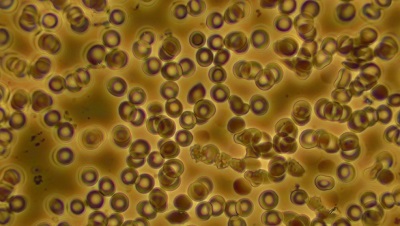
Снимка 13

Плазмите на Кеше будят кръвните клетки!
В края на 2020 година ви разказахме за антивирусната плазма, основана от изобретателя Мехран Кеше, прилагана в Иран в битката против COVID-19, която към този момент се употребява и у нас. Ядреният физик Кеше счита, че всичко, което ни заобикаля, са енергийни полета, които си взаимодействат, а вирусите се притеглят от силите на другите органи в тялото. Мехран Кеше съумява да сътвори субстанция, която назовава плазма (тя е друга от плазмата във физиката), със сходни качества на полетата на органите. Тъй като в природата по-голямата сила зарежда поле с по-малка, плазмата на Кеше е с по-ниска сила от тази на вируса, с цел да го обезсили. Така заболяването си отива бързо. Ако пък здрав човек приема постоянно вода, заредена с тази плазма, тогава тя защищава организма от болестта. (Виж брой 12/2020)
Зареждането на вода става, като шишенцата с плазма Аnti-virus се слагат до стъклен съд с вода или непосредствено в него, без да се отварят. След 6 ч. водата към този момент е лековита. След това единствено се долива. Ако човек е болен, би трябвало да постанова кърпички с плазмена вода върху гърдите и главата и да прави инхалации. Според отчет от Иран 90% от пациентите се възвръщат от 3 до 7 дни, а 50% се усъвършенстват до 48 часа.
Но по какъв начин работи това ново изобретение? Как трансформира структурата на водата и на кръвта при хора, които пият плазмена вода? Помолихме Иван Тодоров, оператор по комплицирани осведомителни системи и другар на Списание 8, да проучва измененията посредством наблюдаване с тъмнополеви микроскоп.
Когато преди дни направихме микроскопско снимане на вода, заредена с продуктите на Plasma Science - Plasma Science Pulvex, Mineralium и Anti-virus, (успешни в битката с COVID-19), наблюдавайки изображенията, породи естествено въпросът – „ Какво в действителност значи това? “. Затова счетох за подходящо да дам някои уточнения. От многогодишните ми проучвания на водата съм стигнал до няколко безапелационни извода – водата има памет за всяко прикосновение на индивида с нея, за всяко събитие, на което е очевидец, и за всяко вещество, докоснало нейната повърхнина. Нещо повече, тя може да покаже посредством облици и картини каква е същностната природа на веществото, с което е влезнала в прикосновение. Ще дам образец.
ПЛАЗМАТА АКТИВИРА ВОДАТА
Pulvex GANS (друг артикул на компанията Plasma Science) е направен въз основа на пчелен прашец, който съдържа голям брой потребни за индивида микро- и макроелементи. Пчелите деликатно и търпеливо събират цветния прашец, като чудесно знаят при кой цвят да отидат в най-подходящото за събиране време. Старателно складират на задните си крачка прашеца, до момента в който доближи несъмнено тегло, след което бързо го транспортират до кошера, с цел да бъде модифициран в по този начин обичания от всички нас медец…
И в случай че погледнем фотографията на вода, заредена с Pulvex GANS, снимана под микроскоп (Виж илюстрации 1 и 2), ще забележим... по какъв начин пчелите обикалят от цвят на цвят. Изумително, нали?
 1 - Пчелите обикалят цвят след цвят.
1 - Пчелите обикалят цвят след цвят.  2 - За да съберат пъстър прашец!
2 - За да съберат пъстър прашец! Прелюбопитни са и фотографиите на вода, заредена с плазмите на Кеше GANS Anti-virus 1 и 2. (Водата се зарежда, като шишенцата с продуктите се слагат до или в съд с вода, без наличието да се изсипва! - бел. ред.)
Снимките на контролната проба - вода от извор №1, Горна баня (илюстрации 3 и 4), демонстрират умерени включвания и загатнати флорални кристализации, които са типични за множеството изворни води в България.
 3 - Контрола
3 - Контрола  4 - Контрола
4 - Контрола Трите проби, заредени с GANS Anti-virus 1; Anti-virus 2 поотделно и дружно, демонстрираха забавна картина (Виж фотоси 5-8).
 5 - Anti-virus 1
5 - Anti-virus 1  6 - Anti-virus 1
6 - Anti-virus 1  7 - Anti-virus 2
7 - Anti-virus 2  8 - Anti-virus 1 и 2 дружно
8 - Anti-virus 1 и 2 дружно Както се вижда от фотографиите, информацията и силата, които се съдържат в плазмата на двата продукта, трансформират структурата на водата коренно в позитивна посока. Активизират всички минерали, включени по натурален път в нея, и придават на заредената вода кардинално нови качества. При това двата продукта дружно демонстрират образуването на мощни полеви осведомителни и енергийни структури, които могат да имат мощно и бързо позитивно влияние върху човешкия организъм.
Тялото ни е формирано над 70% от вода. Затова преносът на хармоничната информация и мощна сила в него е в положение за броени минути да промени общото му здравословно положение към по-добро.
КРЪВТА съдебна експертиза ПРОМЕНЯТочно това сподели и наблюдението на капка жива кръв при 7 души доброволци 20 минути след приема на чаша вода, заредена с Anti-virus 1 и 2. При всички настъпи осезаема и забележима смяна – изчезнаха тромбоцитни и еритроцитни агрегации, мощно понижиха кръвните кафези с деформирани мембрани, усъвършенства се подвижността (реологията) и виталността на следените кафези. Видно бе и дейното обособяване на отработени субстанции и отрови в кръвната плазма, което е доказателство за мощно активиране на развой на ликвидиране на организма от отрови.
От опит мога да споделя, че не са по никакъв начин доста продуктите в нашия свят, които могат да предизвикат толкоз бърз и динамичен развой на смяна в общото положение на кръвта у индивида. А там, където има естетика, има и положително здраве. Просто тъй като благодарение на сходни артикули човешкият организъм получава опцията добре да се храни и добре да се чисти на клетъчно равнище. В него се задействат всички микро- и макроелементи, метали и минерали, което дава опция на тялото да рестартира процесите на самоконтрол, саморегулация и самоизцеление. По този метод ние можем да се освободим от редица неразположения по най-естествения за нас метод – посредством качествена информация и мощна сила, доставени посредством заредената вода до всяка клетка в нашето тяло.
Методът на оксидологията (наблюдение под микроскоп на жива кръв) разрешава да се създадат избрани изводи за общото положение на човешкия организъм в сходство с качеството на следените кръвни кафези, реологията на кръвта и включванията в кръвната плазма.
 фотография 10
фотография 10  Снимка 11
Снимка 11 Снимка 12
Снимка 12 Снимка 13
Снимка 13  Снимка 14
Снимка 14 На фотоси 10 и 11 се виждат тромбоцитни и еритроцитни агрегации в началната фаза на проучването при доброволец 2. Снимка 12 - 20 минути след изпиване на 250 мл вода, заредена с антивирусна плазма, агрегациите ги няма към този момент.
Контролната фотография 13 на доброволец 4 демонстрира, че той е в положително общо положение. От фотография 14, направена 20 минути след изпиване на 250 мл заредена вода, се вижда по какъв начин се задействат процеси на почистване на организма.

Иван Тодоров приключва виетнамска лингвистика, източни езици и култури в Петербургския държавен университет, Русия. Бил е сътрудник на Българската телеграфна организация в Югоизточна Азия. Специалист е в региона на комплицираните осведомителни системи. Занимава се с практическа радиестезия и геопатология.
plasma-science.bg
За Anti-virus: plasma-science.bg/what-is-antivirus
За Pulvex: plasma-science.bg/what-is-pulvex
facebook.com/plasmatech
Източник: spisanie8.bg

КОМЕНТАРИ





